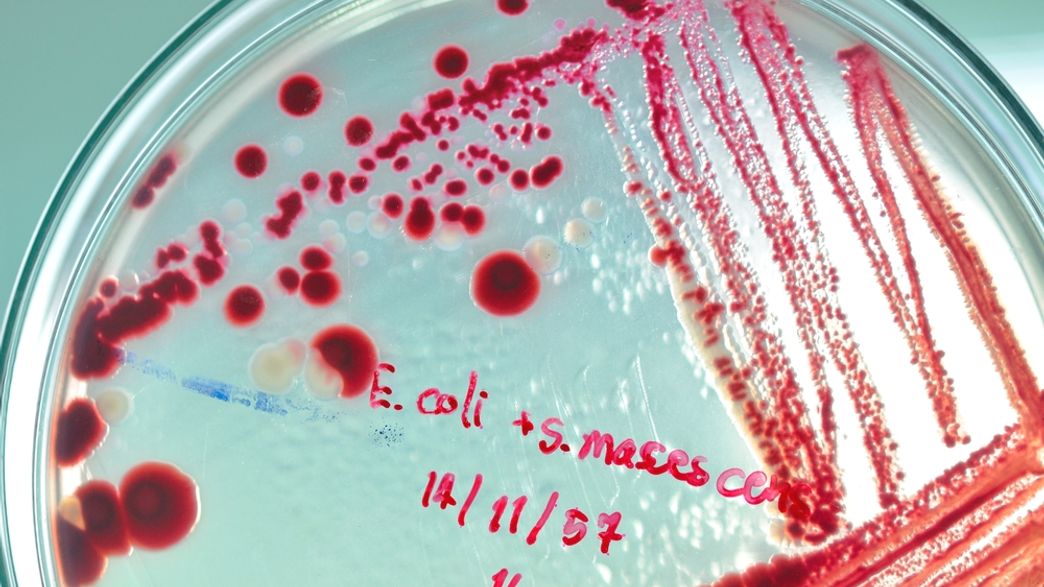

Modern Problem Solving
@ModProblemSolv
Shifting my X to track research I do into different opinions in bio, politics, health, and consciousness.
Bạn có thể thích
Three years ago I got sick from something most people overlook: mold exposure. Today, that journey comes full circle: we’re announcing MoldCo’s $8M Seed (total $11M), led by @cantos + @collabfund, to build the new standard of care for mold and chronic inflammation. The mission…
Grok 4 + Emergent is basically cheating. I used the smartest AI model inside the fastest no-code builder. The result? Unfair. Here are 4 wild builds we made with this combo 👇

In a recent meeting with our product team, I discussed the concept of designing for AI in SaaS products, something I call AI Primacy. I was surprised when members of the team expressed skepticism that AI could automate the majority of use cases in real estate, accounting, and…
I spend a lot of time working on calming the nervous system and learning about it. One thing i added to my approach about 2 months ago was CO2 based breath training. CO₂ is great for this because it helps gently retrain the limbic system to respond with calm instead of panic.…
DIY Powerwall Builders Are Using Recycled Laptop Batteries to Power Their Homes - VICE vice.com/en_us/article/…
This article has a summary of the findings from the Imperial College London COVID analysis. The findings are pretty crazy in terms of the different projections and worth a detailed read: oregonlive.com/coronavirus/20…
Great article comparing the testing response between the US and South Korea (1st cases 1 day apart) esquire.com/news-politics/…
I'm going to start savings articles i like a read here. Here is one about beyond meat forbes.com/sites/katrinaf…
Sometimes doing the same thing over &over is *not* the definition of insanity. Sometimes it's hope, persistence & belief it will get better
HARD Goals, Not SMART Goals, Are The Key To Career Development flip.it/o5x65B
flip.it
HARD Goals, Not SMART Goals, Are The Key To Career Development
Good employees want the opportunity to grow and develop on the job. And here’s the great news, a simple, 15-minute conversation, that focuses on HARD Goals, will encourage your people to take a more...
These are the five most valuable companies on earth.




United States Xu hướng
- 1. Chet 9,537 posts
- 2. #NBAonNBC 1,387 posts
- 3. Rockets 34.6K posts
- 4. #ThunderUp 3,094 posts
- 5. Steven Adams 1,445 posts
- 6. Russ 31.4K posts
- 7. The NBA 116K posts
- 8. Roundball Rock 7,147 posts
- 9. Lakers 45.4K posts
- 10. Marchand 5,016 posts
- 11. Mike Tirico 1,155 posts
- 12. Reggie Miller N/A
- 13. Kevin Durant 12.1K posts
- 14. Warriors 61.9K posts
- 15. Jen Psaki 3,269 posts
- 16. NASA 78.7K posts
- 17. Amen Thompson 2,726 posts
- 18. Shai 13.8K posts
- 19. Adam Silver 2,409 posts
- 20. Sean Payton 3,737 posts
Something went wrong.
Something went wrong.